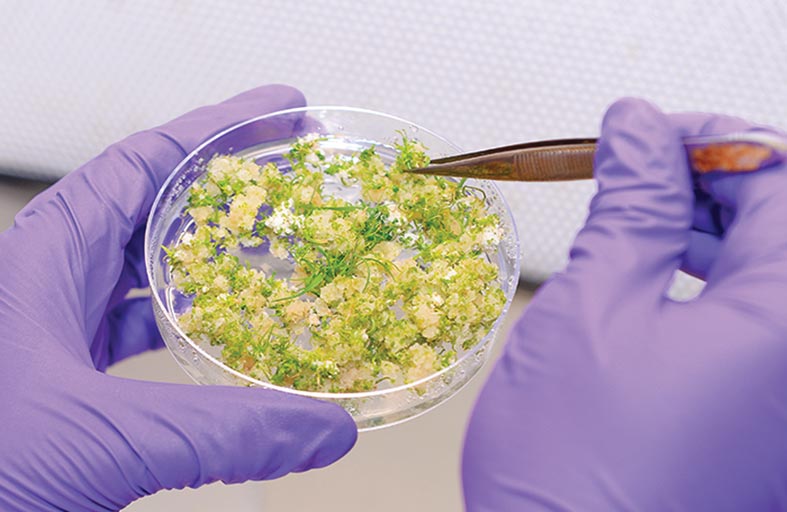
باحثون في مركز خليفة للهندسة الوراثية يفككون جينوم شجرة الغاف

رئيس الدولة ونائباه يهنئون ملك البحرين بذكرى اليوم الوطني لبلاده
محلية
شرطة أبوظبي والهلال الأحمر تطلقان «يتربى في عزكم» للتوعية بسلامة الأطفال في المركبة
أطلقت شرطة أبوظبي بالتعاون مع هيئة الهلال الأحمر الإماراتي مبادرة "يتربى في عزكم" بمستشفى كند بالعين ، احتفاءً بالمواليد الجدد وإدخال البهجة والسرور على نفوس الأسر ونشر الثقافة بسلامة الأطفال بالمركبات. ووزعت إدارة ... إقرأ المزيد
شركة إعمار لإدارة مراكز التسوّق تطلق عروض العودة إلى المدارس في مراكزها التجارية
أطلقت شركة إعمار لإدارة مراكز التسوّق عروضاً مميزّة تُلبّي كافة متطلّبات الطلّاب مع اقتراب موعد العودة إلى المدرسة، وذلك عبر سلسلة من متاجر أبرز العلامات التجارية المتواجدة في كلّ من "دبي مول"، ... إقرأ المزيد
طلبة من جامعة بوسان بكوريا الجنوبية يستكملون برنامجاً تدريبياً لتعلم اللغة العربية في جامعة الإمارات
استكمل عدد من طلبة جامعة بوسان بكوريا الجنوبية للدراسات الأجنبية برنامج "تعليم مهارات اللغة العربية للناطقين بغيرها"، على مدى أربعة أسابيع من التدريب المكثّف في مركز التعليم المستمر بجامعة الإمارات العربية المتحدة، ... إقرأ المزيد
تراث الإمارات ينظم محاضرة «زايد والوطن» في ذكرى 6 أغسطس
نظم نادي تراث الإمارات - مركز زايد للدراسات والبحوث، محاضرة افتراضية بعنوان «زايد والوطن»، قدمها معالي الدكتور عبدالله بلحيف النعيمي، وأدارها الإعلامي محمد عبدالكريم. وجاءت المحاضرة احتفاء بذكرى تولي المغفور له الشيخ زايد ... إقرأ المزيد
شرطة دبي تشارك في فعاليات «المعسكرات الصيفية»
تشارك القيادة العامة لشرطة دبي بالتعاون مع رابطة المحترفين الإماراتية في فعاليات مبادرة "المعسكرات الصيفية"، في نادي النصر الثقافي الرياضي، وتستمر المبادرة 4 أيام. وأكد العميد خالد علي شهيل مدير الإدارة العامة لإسعاد ... إقرأ المزيد
شرطة دبي تطلق أول دبلوم لغة إشارة للعنصر النسائي
بناءً على توجهات القيادة العامة لشرطة دبي، أطلقت الإدارة العامة للتدريب بالتعاون مع المجلس النسائي لشرطة دبي، أول دبلوم مُتخصص في لغة الإشارة للعنصر النسائي، وذلك بهدف تعزيز قدراتهن في التواصل وتقديم ... إقرأ المزيد
فريق بحثي من مركز الإمارات لأبحاث التنقل بجامعة الإمارات يستعرض تطورات «مشروع الطرق الذكية»
قدم فريق بحثي من مركز الإمارات لأبحاث التنقل عرضاً تعريفياً شاملاً حول تطورات "مشروع الطرق الذكية" الذي تم إطلاقه من قبل المركز مؤخراً، وذلك بحضور الأستاذ الدكتور غالب الحضرمي البريكي- مدير الجامعة، ... إقرأ المزيد
جامعة أبوظبي تحتفي بتخريج 4,770 مهندساً منذ تأسيسها
• تخصصات هندسية وحاسوبية معتمدة عالمياً تواكب المتطلبات الحالية والمستقبلية لسوق العمل احتفت كلية الهندسة في جامعة أبوظبي، واحدة من أكبر كليات الهندسة في دولة الإمارات العربية المتحدة، بمنحها 4,940 شهادة جامعية في ... إقرأ المزيد
© 2013 جميع الحقوق محفوظة لجريدة الفجر.